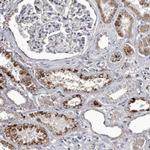
Cathepsin A Antibody in Immunohistochemistry (IHC)

Search
Invitrogen
Cathepsin A Polyclonal Antibody
{{$productOrderCtrl.translations['antibody.pdp.commerceCard.promotion.promotions']}}
{{$productOrderCtrl.translations['antibody.pdp.commerceCard.promotion.viewpromo']}}
{{$productOrderCtrl.translations['antibody.pdp.commerceCard.promotion.promocode']}}: {{promo.promoCode}} {{promo.promoTitle}} {{promo.promoDescription}}. {{$productOrderCtrl.translations['antibody.pdp.commerceCard.promotion.learnmore']}}
产品信息
PA5-56629
种属反应
宿主/亚型
分类
类型
抗原
偶联物
形式
浓度
规格
纯化类型
保存液
内含物
保存条件
运输条件
RRID
产品详细信息
Immunogen sequence: PCTNTTAAST YLNNPYVRKA LNIPEQLPQW DMCNFLVNLQ YRRLYRSMNS QYLKLLSSQK YQILLYNGDV DMACNFMGDE WFVDSLNQKM EVQRRPWLVK YGDSGEQIAG FVKEFSHIAF LTIKGAGHMV PTDKPLAA
Highest antigen sequence identity to the following orthologs: Mouse - 91%, Rat - 61%.
靶标信息
The cathepsin family of proteolytic enzymes include several diverse classes of proteases. Cathepsins B, L, H, K, S and O comprise the cysteine protease class. Cathepsins D and E comprise the aspartyle protease class. The serine protease class includes cathepsin G. Cathepsins function in cellular metabolism and participate in peptide biosynthesis and protein degradation. Cathepsin A, a serine carboxypeptidase, exists in a high molecular weight lysosomal complex with b-galactosidase (b-gal) and a-neuraminidase (Neu1). Cathepsin A functions to protect b-gal and Neu1 from intralysosomal proteolysis. Deficiencies in cathepsin A lead to deficiencies in b-gal and Neu1. The gene encoding human cathepsin A maps to chromosome 20q13.12. Mutations in this gene cause glactosialidosis, a lysosomal storage disorder resulting from the b-gal and Neu1 deficiencies.
仅用于科研。不用于诊断过程。未经明确授权不得转售。
篇参考文献 (0)
生物信息学
蛋白别名: beta-galactosidase 2; beta-galactosidase protective protein; Carboxypeptidase C; Carboxypeptidase L; carboxypeptidase Y-like kininase; carboxypeptidase-L; Cathepsin A; deamidase; lysosomal carboxypeptidase A; Lysosomal protective protein; PPCA; Protective protein cathepsin A; Protective protein for beta-galactosidase; protective protein precursor; unnamed protein product; urinary kininase
基因别名: CTSA; GLB2; GSL; NGBE; PPCA; PPGB
UniProt ID: (Human) P10619
Entrez Gene ID: (Human) 5476